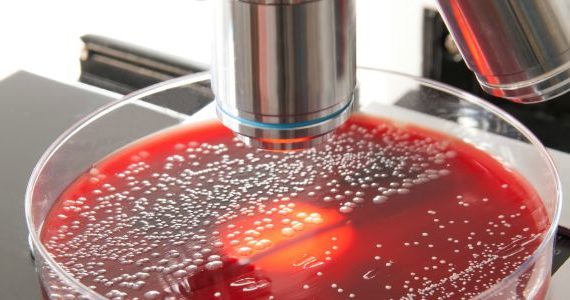

Le troisième rapport conjoint de l’EFSA et de l’ECDC sur la résistance aux antimicrobiens des bactéries zoonotiques affectant les hommes, les animaux et les aliments indique la présence continue d’une résistance à un éventail d’antimicrobiens chez Salmonella et Campylobacter. Cependant, le risque demeure pour l’instant sous contrôle.
Ces deux bactéries sont les principales sources d’infections d’origine alimentaire dans l’Union européenne. Le rapport, qui fait suite à des analyses menée en 2011, souligne qu’une proportion élevée de bactéries Campylobacter se sont révélées résistantes à un antimicrobien d’importance critique, la ciprofloxacine. A l’opposé, une faible résistance a été enregistrée pour l’érythromycine, un deuxième antimicrobien d’importance critique.
Globalement, dans l’Union Européenne, la co-résistance aux antimicrobiens d’importance critique était faible en 2011, ce qui indique que des options de traitement restent disponibles à ce jour pour des infections graves par ces bactéries.
Pour Salmonella, la multi-résistance aux médicaments s’est révélée globalement élevée dans l’UE. Chez l’homme, une proportion élevée de Salmonella est résistante à des antimicrobiens couramment utilisés, ce qui est également le cas chez certains animaux, en particulier les porcs et les dindes.
Néanmoins, les niveaux de co-résistance à des antimicrobiens d’importance critique sont faibles dans les Salmonella chez l’homme, les animaux producteurs de denrées alimentaires et dans les denrées alimentaires.
La multi-résistance aux médicaments, la co-résistance et la résistance à des antimicrobiens couramment utilisés doivent donc être attentivement surveillées. La résistance aux antimicrobiens constitue en effet une menace sérieuse pour la santé publique, car elle entraîne une augmentation des coûts de santé, un allongement de la durée des séjours hospitaliers, des échecs de traitement et, parfois, le décès de patients.
EFSA, communiqué de presse, 16 mai 2013. The European Union Summary Report on antimicrobial resistance in zoonotic and indicator bacteria from humans, animals and food in 2011.